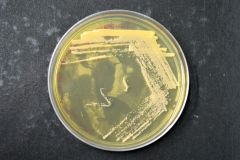
novas

Eventos passados
Confira os próximos eventos![]() Seminários em Genética e Biologia Evolutiva
Seminários em Genética e Biologia Evolutiva
Título: Thomson Reuters Integrity: Otimizando a Inovação Farmacológica e de Biomarcadores em Base ao Conhecimento
Palestrante: Antero Macedo - Thomson Reuters
Data: 03.10
Hora: 14h
Local: Sala 2 – Edifício Minas Gerais
 Seminário EcoEncontros - 02.10 - 13h
Seminário EcoEncontros - 02.10 - 13h
Título: “Sexual dichromatism and Rensch’s rule in wing pigmentation in New World dragonflies”
Palestrante: Dr. Eduardo Santos (Departamento de Ecologia - IB/USP)
Data: 02.10.14 (quinta-feira)
Hora:13h
Local:AG da Zoologia
Novas abordagens da pesquisa biológica
Novas abordagens da pesquisa biológica
Título: Enfoques genômicos e computacionais em estudos de organismos envolvidos na cadeia produtiva do bioetanol.
Palestrante: Diego Riaño (Group of Computational and Evolutionary Biology (BCE) at the Labóratorio Nacional de Ciência e Tecnologia do Bioetanol (CTBE)
Data: 03.10.14
Hora: 12-14h
Local: AG da Zoo (IB/USP)
 Título:Modulação do sistema catecolaminérgico pelos receptores glutamatérgicos e de angiotensina II no bulbo de ratos
Título:Modulação do sistema catecolaminérgico pelos receptores glutamatérgicos e de angiotensina II no bulbo de ratos
Aluno(a):Sergio Marinho da Silva
Orientador:Dr(a). Debora Rejane Fior Chadi
Data:06.10.14
Hora:14h
Local:Sala Erasmo Garcia Mendes (Seminários) de Depto Fisiologia
 Título: Como o estudo do comportamento humano pode contribuir à conservação de espécies?
Título: Como o estudo do comportamento humano pode contribuir à conservação de espécies?
Palestrante: Carla Morsello - EACH/USP
Data: 28.11.14
Hora: 12h-13h
Local: AG da Zoo (IB/USP)

